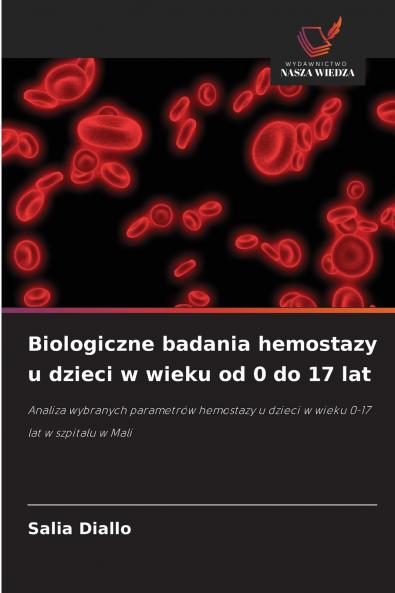
Biologiczne badania hemostazy u dzieci w wieku od 0 do 17 lat

Polish
Paperback
₹5634
₹7427
24.14% OFF
(All inclusive*)
Delivery Options
Please enter pincode to check delivery time.
*COD & Shipping Charges may apply on certain items.
Review final details at checkout.
Looking to place a bulk order? SUBMIT DETAILS
About The Book
Description
Author
Hemostaza obejmuje wszystkie mechanizmy związane z zatrzymywaniem krwawienia. Kiedy naczynie krwionośne zostanie uszkodzone zadaniem organizmu jest jego naprawa. Niektóre parametry takie jak czas protrombinowy międzynarodowy współczynnik znormalizowany i aktywowany czas częściowej tromboplastyny odgrywają rolę zarówno w diagnostyce jak i monitorowaniu terapeutycznym tej patologii. Celem tego badania było zbadanie hemostazy u dzieci w wieku od 0 do 17 lat. Badanymi parametrami były wskaźnik protrombinowy (PT) INR i aktywowany czas częściowej tromboplastyny lub kaolin (APTT/TCK) a do badania włączono 100 pacjentów z których 57% stanowili mężczyźni a 43% kobiety. Większość tych pacjentów pochodziła z gminy 6 (61%) 16% z gminy 5 10% z obrzeży Bamako (tj. pacjenci spoza gmin Bamako) 8% z gminy 1 i 5% z gminy 4. W odniesieniu do powodów przepisywania hemostazy okazało się że parametr ten był przepisywany pacjentom głównie w celu oceny przedoperacyjnej (90% przypadków). Analizę tę sugerowano również w przypadkach podejrzenia infekcji (4%).
Delivery Options
Please enter pincode to check delivery time.
*COD & Shipping Charges may apply on certain items.
Review final details at checkout.
Details
ISBN 13
9786208924676
Publication Date
-31-05-2025
Pages
-56
Weight
-90 grams
Dimensions
-152x229x3.41 mm